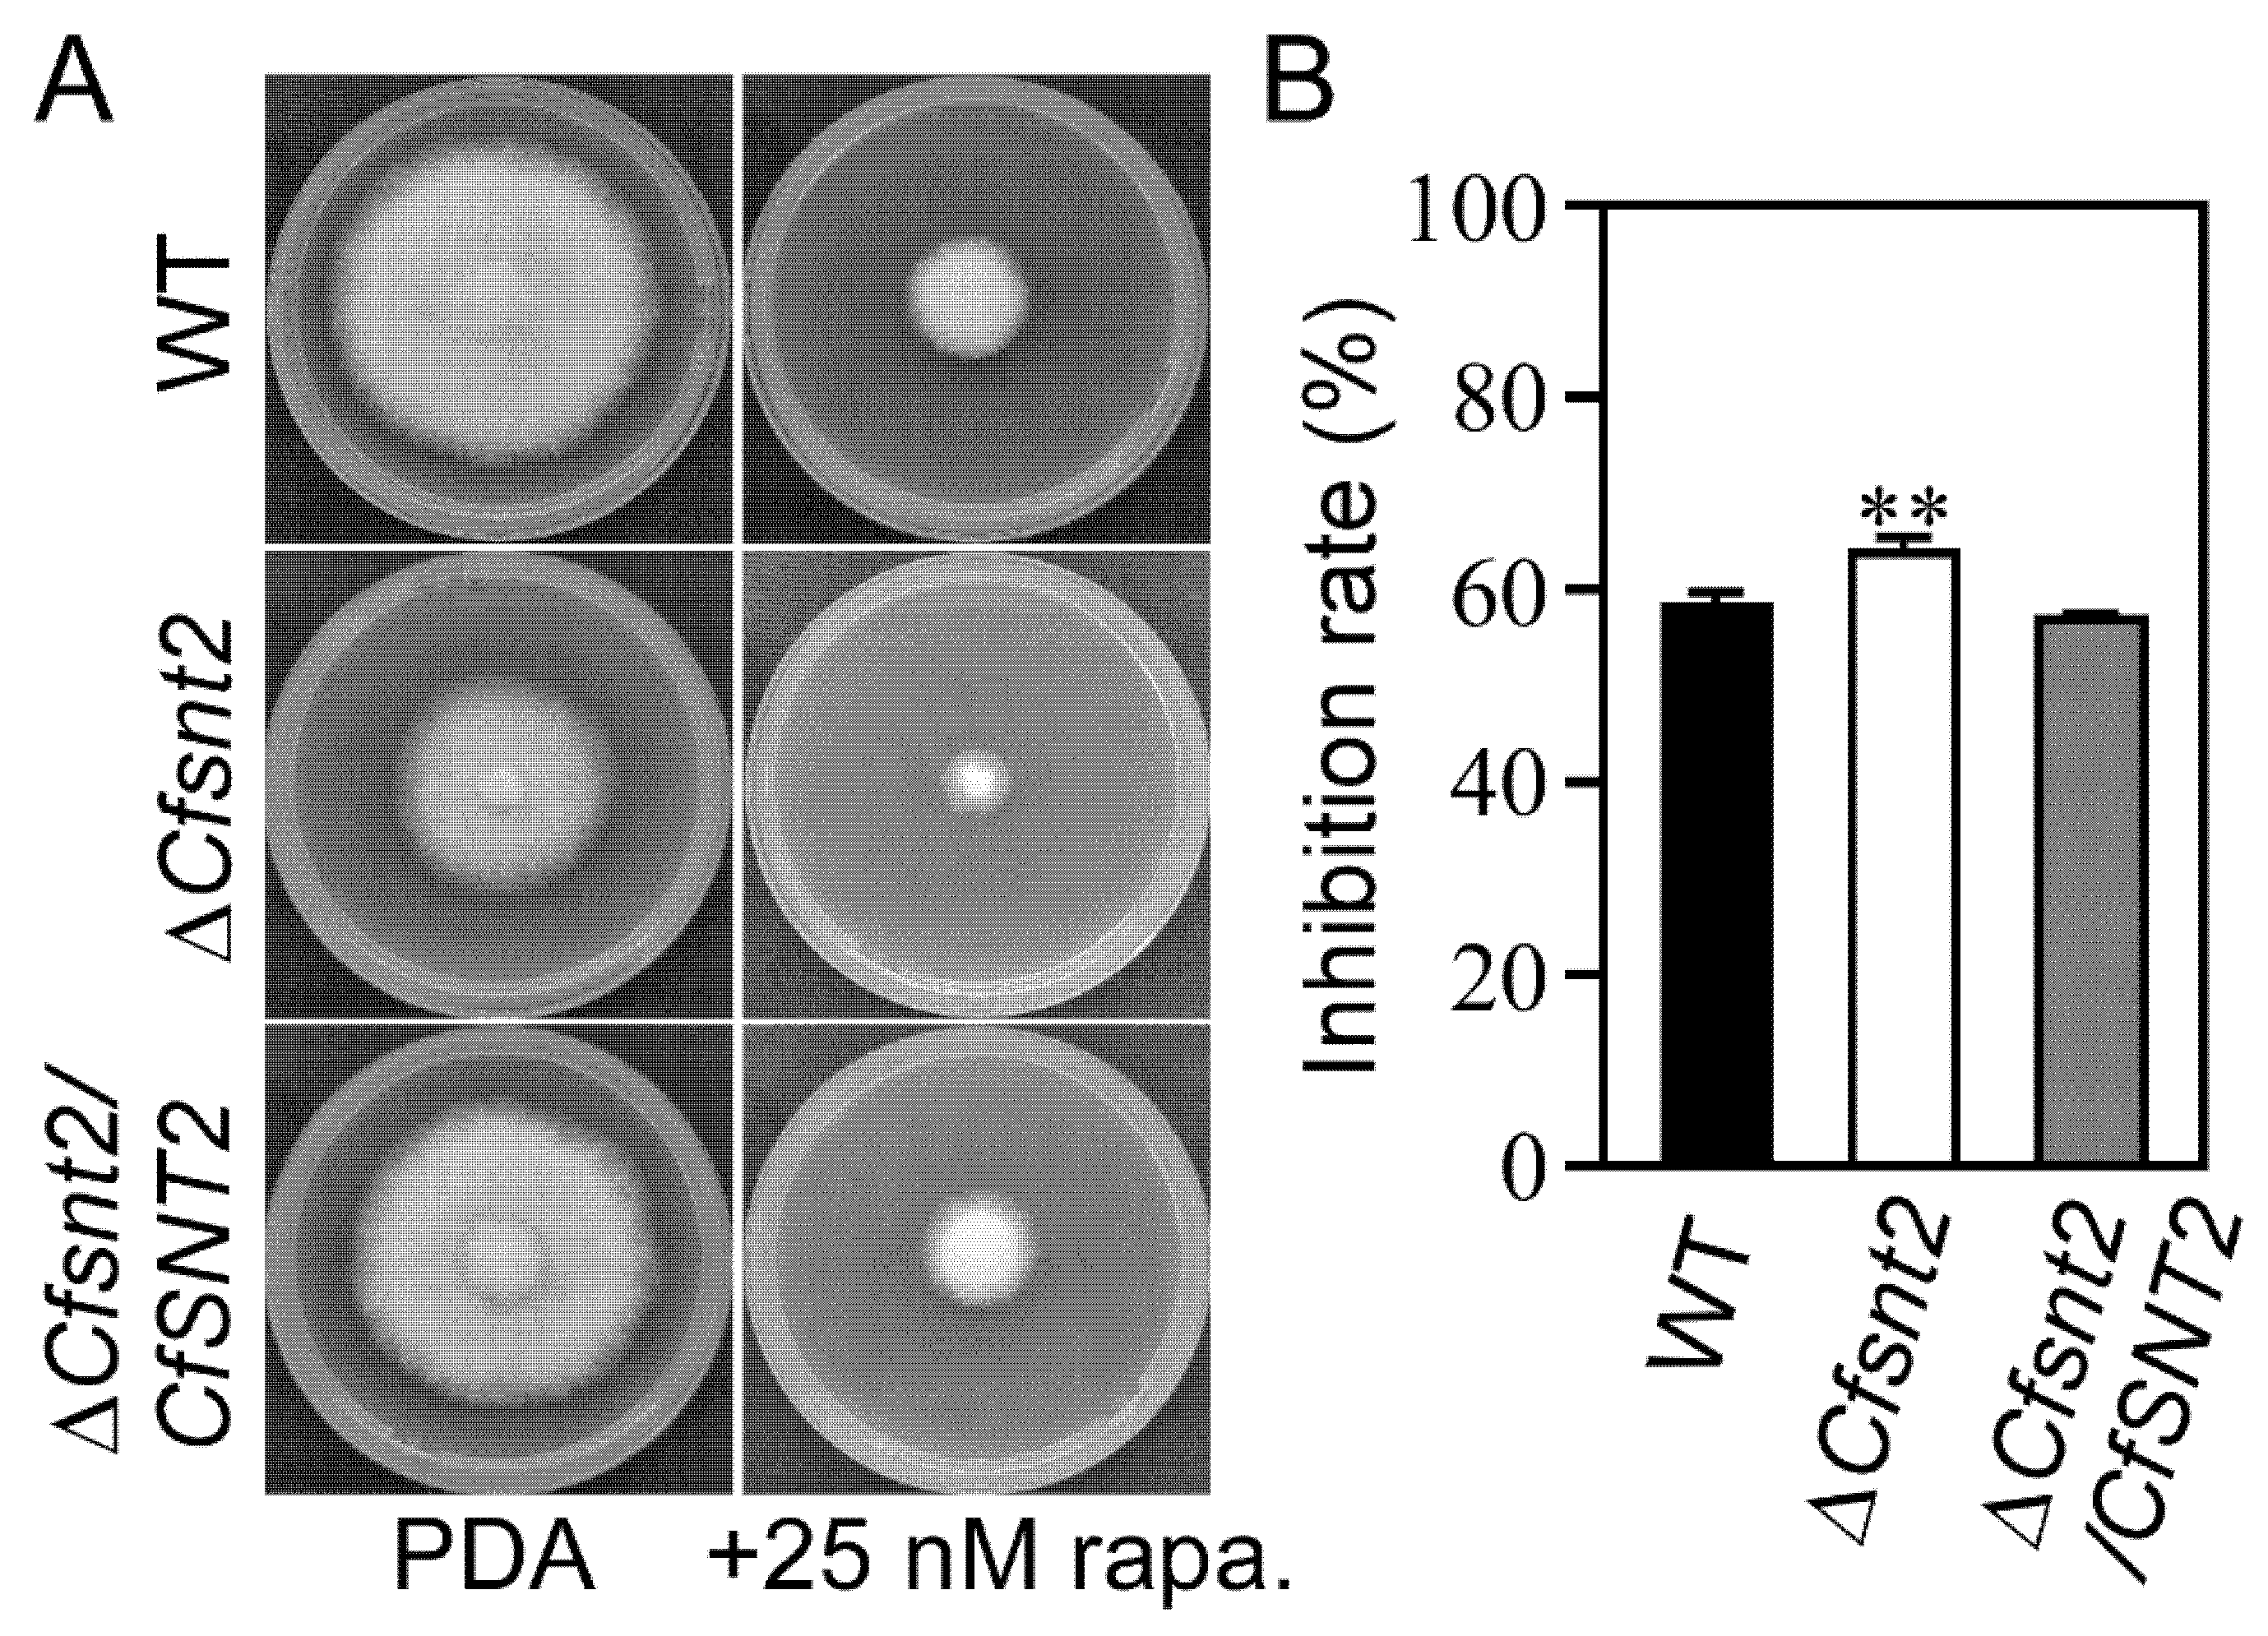
Jof 08 00974 g006 Jof 08 00974 g006

The CfSnt2-Dependent Deacetylation of Histone H3 Mediates Autophagy and Pathogenicity of Colletotrichum fructicola
Abstract
1. Introduction
2. Results
2.1. CfSnt2 Is Localized to the Nucleus and Mediates H3 Deacetylation
2.2. Transcriptomic Analysis of the WT and ΔCfsnt2 Mutant
2.3. Gene Ontology Enrichment of the DEGs
2.4. KEGG Pathway Enrichment of the DEGs
2.5. CfSnt2 Mediates the Expression of Multiple CfATG Genes
2.6. CfSnt2 Is Involved in the Rapamycin Response
2.7. CfSnt2 Negatively Regulates Autophagy
2.8. CfSnt2 Regulates Pathogenicity and the Responses to Oxidative and ER Stresses
3. Discussion
4. Materials and Methods
4.1. Strains and Culture Conditions
4.2. Generation of the CfSnt2-GFP, H1-RFP, and GFP-CfSnt2 Constructs
4.3. Localization Assays
4.4. Protein Extraction and Immunoblot Analysis
4.5. Transcriptome Sequencing and Analysis
4.6. QRT-PCR Assays
4.7. Stress Response Analysis
4.8. Pathogenicity Assays
4.9. Statistical Analysis
Supplementary Materials
Author Contributions
Funding
Institutional Review Board Statement
Informed Consent Statement
Data Availability Statement
Conflicts of Interest
References
- Chen, Y.Z.; Wang, B.M.; Chen, J.J.; Wang, X.N.; Wang, R.; Peng, S.F.; Chen, L.S.; Ma, L.; Luo, J. Identification of Rubisco rbcL and rbcS in Camellia oleifera and their potential as molecular markers for selection of high tea oil cultivars. Front. Plant Sci. 2015, 6, 189. [Google Scholar] [CrossRef] [PubMed]
- Di, T.M.; Yang, S.L.; Du, F.Y.; Zhao, L.; Li, X.H.; Xia, T.; Zhang, X.F. Oleiferasaponin A(2), a novel saponin from camellia oleifera Abel. seeds, inhibits lipid accumulation of hepG2 cells through regulating fatty acid metabolism. Molecules 2018, 23, 3296. [Google Scholar] [CrossRef]
- Wang, X.; Zeng, Q.; Del Mar Contreras, M.; Wang, L. Profiling and quantification of phenolic compounds in Camellia seed oils: Natural tea polyphenols in vegetable oil. Food Res. Int. 2017, 102, 184–194. [Google Scholar] [CrossRef]
- Gong, W.; Xiao, S.; Wang, L.; Liao, Z.; Chang, Y.; Mo, W.; Hu, G.; Li, W.; Zhao, G.; Zhu, H.; et al. Chromosome-level genome of Camellia lanceoleosa provides a valuable resource for understanding genome evolution and self-incompatibility. Plant J. 2022, 110, 881–898. [Google Scholar] [CrossRef] [PubMed]
- Gong, W.F.; Song, Q.L.; Ji, K.; Gong, S.F.; Wang, L.K.; Chen, L.; Zhang, J.; Yuan, D.Y. Full-length transcriptome from Camellia oleifera seed provides insight into the transcript variants involved in oil biosynthesis. J. Agric. Food Chem. 2020, 68, 14670–14683. [Google Scholar] [CrossRef]
- Li, H.; Zhou, G.Y.; Liu, J.A.; Xu, J. Population genetic analyses of the fungal pathogen Colletotrichum fructicola on tea-oil trees in China. PLoS ONE 2016, 11, e0156841. [Google Scholar] [CrossRef] [PubMed]
- Chen, Z.H.; He, L.; Chen, J.; Chen, X.; Luo, J.; Zhang, S.P. Histone deacetylase CfSnt2 regulates the growth, development and pathogenicity of Colletotrichum fructicola. Mycosystema 2022, 41, 926–938. [Google Scholar]
- Singh, R.K.; Gonzalez, M.; Kabbaj, M.H.M.; Gunjan, A. Novel E3 ubiquitin ligases that regulate histone protein levels in the budding yeast Saccharomyces cerevisiae. PLoS ONE 2012, 7, e36295. [Google Scholar] [CrossRef] [PubMed]
- Yang, Y.; Zhang, Z.L.; Li, Y.X.; Zhu, X.G.; Liu, Q. Identifying cooperative transcription factors by combining ChIP-chip data and knockout data. Cell Res. 2010, 20, 1276–1278. [Google Scholar] [CrossRef] [PubMed][Green Version]
- Baker, L.A.; Ueberheide, B.M.; Dewell, S.; Chait, B.T.; Zheng, D.; Allis, C.D. The yeast Snt2 protein coordinates the transcriptional response to hydrogen peroxide-mediated oxidative stress. Mol. Cell. Biol. 2013, 33, 3735–3748. [Google Scholar] [CrossRef] [PubMed]
- Denisov, Y.; Yarden, O.; Freeman, S. The transcription factor SNT2 is involved in fungal respiration and reactive oxidative stress in Fusarium oxysporum and Neurospora crassa. Physiol. Mol. Plant Pathol. 2011, 76, 137–143. [Google Scholar] [CrossRef]
- Denisov, Y.; Freeman, S.; Yarden, O. Inactivation of Snt2, a BAH/PHD-containing transcription factor, impairs pathogenicity and increases autophagosome abundance in Fusarium oxysporum. Mol. Plant Pathol. 2011, 12, 449–461. [Google Scholar] [CrossRef]
- He, M.; Xu, Y.P.; Chen, J.H.; Luo, Y.; Lv, Y.; Su, J.; Kershaw, M.J.; Li, W.T.; Wang, J.; Yin, J.J.; et al. MoSnt2-dependent deacetylation of histone H3 mediates MoTor-dependent autophagy and plant infection by the rice blast fungus Magnaporthe oryzae. Autophagy 2018, 14, 1543–1561. [Google Scholar] [CrossRef]
- Liu, Y.; Schiff, M.; Czymmek, K.; Talloczy, Z.; Levine, B.; Dinesh-Kumar, S.P. Autophagy regulates programmed cell death during the plant innate immune response. Cell 2005, 121, 567–577. [Google Scholar] [CrossRef]
- Noda, T.; Ohsumi, Y. Tor, a phosphatidylinositol kinase homologue, controls autophagy in yeast. J. Biol. Chem. 1998, 273, 3963–3966. [Google Scholar] [CrossRef]
- Dementhon, K.; Saupe, S.J.; Clave, C. Characterization of IDI-4, a bZIP transcription factor inducing autophagy and cell death in the fungus Podospora anserina. Mol. Microbiol. 2004, 53, 1625–1640. [Google Scholar] [CrossRef]
- Ohsumi, Y. Historical landmarks of autophagy research. Cell Res. 2014, 24, 9–23. [Google Scholar] [CrossRef]
- Talbot, N.J.; Kershaw, M.J. The emerging role of autophagy in plant pathogen attack and host defence. Curr. Opin. Plant Biol. 2009, 12, 444–450. [Google Scholar] [CrossRef]
- Li, L.; Zhu, X.M.; Liu, X.H.; Lin, F.C. Methods to Study Autophagocytosis in Magnaporthe oryzae. Methods Mol. Biol. 2021, 2356, 173–185. [Google Scholar]
- Zhu, X.M.; Li, L.; Wu, M.; Liang, S.; Shi, H.B.; Liu, X.H.; Lin, F.C. Current opinions on autophagy in pathogenicity of fungi. Virulence 2019, 10, 481–489. [Google Scholar] [CrossRef]
- Kershaw, M.J.; Talbot, N.J. Genome-wide functional analysis reveals that infection-associated fungal autophagy is necessary for rice blast disease. Proc. Natl. Acad. Sci. USA 2009, 106, 15967–15972. [Google Scholar] [CrossRef]
- Zhu, X.M.; Li, L.; Cai, Y.Y.; Wu, X.Y.; Shi, H.B.; Liang, S.; Qu, Y.M.; Naqvi, N.I.; Del Poeta, M.; Dong, B.; et al. VASt-domain protein regulates autophagy, membrane tension, and sterol homeostasis in rice blast fungus. Autophagy 2021, 17, 2939–2961. [Google Scholar] [CrossRef]
- Zheng, H.; Miao, P.; Lin, X.; Li, L.; Wu, C.; Chen, X.; Abubakar, Y.S.; Norvienyeku, J.; Li, G.; Zhou, J.; et al. Small GTPase Rab7-mediated FgAtg9 trafficking is essential for autophagy-dependent development and pathogenicity in Fusarium graminearum. PLoS Genet. 2018, 14, e1007546. [Google Scholar] [CrossRef]
- Guo, Y.; Li, H.; Zhou, G.Y.; Liu, J.A.; Zhang, S.P. Functional analysis of the autophagy-related protein CfAtg8 in Colletotrichum fructicola. Mycosystema 2021, 43, 592–602. [Google Scholar]
- Yin, Z.; Chen, C.; Yang, J.; Feng, W.; Liu, X.; Zuo, R.; Wang, J.; Yang, L.; Zhong, K.; Gao, C.; et al. Histone acetyltransferase MoHat1 acetylates autophagy-related proteins MoAtg3 and MoAtg9 to orchestrate functional appressorium formation and pathogenicity in Magnaporthe oryzae. Autophagy 2019, 15, 1234–1257. [Google Scholar] [CrossRef]
- Zhang, S.; Liang, M.; Naqvi, N.I.; Lin, C.; Qian, W.; Zhang, L.H.; Deng, Y.Z. Phototrophy and starvation-based induction of autophagy upon removal of Gcn5-catalyzed acetylation of Atg7 in Magnaporthe oryzae. Autophagy 2017, 13, 1318–1330. [Google Scholar] [CrossRef]
- Wang, J.; Xu, C.Y.; Sun, Q.M.; Xu, J.R.; Chai, Y.R.; Berg, G.; Cernava, T.; Ma, Z.H.; Chen, Y. Post-translational regulation of autophagy is involved in intra-microbiome suppression of fungal pathogens. Microbiome 2021, 9, 131. [Google Scholar] [CrossRef]
- Zhang, S.; Guo, Y.; Chen, S.; Li, H. The Histone acetyltransferase CfGcn5 regulates growth, development, and pathogenicity in the anthracnose fungus Colletotrichum fructicola on the tea-oil tree. Front. Microbiol. 2021, 12, 680415. [Google Scholar] [CrossRef]
- Ding, S.L.; Liu, W.; Iliuk, A.; Ribot, C.; Vallet, J.; Tao, A.; Wang, Y.; Lebrun, M.H.; Xu, J.R. The tig1 histone deacetylase complex regulates infectious growth in the rice blast fungus Magnaporthe oryzae. Plant Cell 2010, 22, 2495–2508. [Google Scholar] [CrossRef]
- Wang, Y.; Zhang, H. Regulation of Autophagy by mTOR Signaling Pathway. Adv. Exp. Med. Biol. 2019, 1206, 67–83. [Google Scholar]
- Marroquin-Guzman, M.; Wilson, R.A. GATA-Dependent Glutaminolysis Drives Appressorium Formation in Magnaporthe oryzae by Suppressing TOR Inhibition of cAMP/PKA Signaling. PLoS Pathog. 2015, 11, e1004851. [Google Scholar] [CrossRef] [PubMed]
- Nakatogawa, H.; Ichimura, Y.; Ohsumi, Y. Atg8, a ubiquitin-like protein required for autophagosome formation, mediates membrane tethering and hemifusion. Cell 2007, 130, 165–178. [Google Scholar] [CrossRef]
- Qian, B.; Liu, X.; Ye, Z.; Zhou, Q.; Liu, P.; Yin, Z.; Wang, W.; Zheng, X.; Zhang, H.; Zhang, Z. Phosphatase-associated protein MoTip41 interacts with the phosphatase MoPpe1 to mediate crosstalk between TOR and cell wall integrity signalling during infection by the rice blast fungus Magnaporthe oryzae. Environ. Microbiol. 2021, 23, 791–809. [Google Scholar] [CrossRef]
- Dobrenel, T.; Caldana, C.; Hanson, J.; Robaglia, C.; Vincentz, M.; Veit, B.; Meyer, C. TOR Signaling and Nutrient Sensing. Annu. Rev. Plant Biol. 2016, 67, 261–285. [Google Scholar] [CrossRef] [PubMed]
- Hemetsberger, C.; Herrberger, C.; Zechmann, B.; Hillmer, M.; Doehlemann, G. The Ustilago maydis effector Pep1 suppresses plant immunity by inhibition of host peroxidase activity. PLoS Pathog. 2012, 8, e1002684. [Google Scholar] [CrossRef]
- Liu, X.; Zhou, Q.; Guo, Z.; Liu, P.; Shen, L.; Chai, N.; Qian, B.; Cai, Y.; Wang, W.; Yin, Z.; et al. A self-balancing circuit centered on MoOsm1 kinase governs adaptive responses to host-derived ROS in Magnaporthe oryzae. Elife 2020, 9, e61605. [Google Scholar] [CrossRef]
- Tang, W.; Jiang, H.; Aron, O.; Wang, M.; Wang, X.; Chen, J.; Lin, B.; Chen, X.; Zheng, Q.; Gao, X.; et al. Endoplasmic reticulum-associated degradation mediated by MoHrd1 and MoDer1 is pivotal for appressorium development and pathogenicity of Magnaporthe oryzae. Environ. Microbiol. 2020, 22, 4953–4973. [Google Scholar] [CrossRef]
- Yin, Z.; Feng, W.; Chen, C.; Xu, J.; Li, Y.; Yang, L.; Wang, J.; Liu, X.; Wang, W.; Gao, C.; et al. Shedding light on autophagy coordinating with cell wall integrity signaling to govern pathogenicity of Magnaporthe oryzae. Autophagy 2020, 16, 900–916. [Google Scholar] [CrossRef]
- Dean, R.; Van Kan, J.A.L.; Pretorius, Z.A.; Hammond-Kosack, K.E.; Di Pietro, A.; Spanu, P.D.; Rudd, J.J.; Dickman, M.; Kahmann, R.; Ellis, J.; et al. The Top 10 fungal pathogens in molecular plant pathology. Mol. Plant Pathol. 2012, 13, 804. [Google Scholar] [CrossRef]
- Bannister, A.J.; Kouzarides, T. Regulation of chromatin by histone modifications. Cell Res. 2011, 21, 381–395. [Google Scholar] [CrossRef]
- Lee, K.K.; Workman, J.L. Histone acetyltransferase complexes: One size doesn’t fit all. Nat. Rev. Mol. Cell Biol. 2007, 8, 284–295. [Google Scholar] [CrossRef]
- Jeon, J.; Kwon, S.; Lee, Y.H. Histone acetylation in fungal pathogens of plants. Plant Pathol. J. 2014, 30, 1–9. [Google Scholar] [CrossRef] [PubMed]
- Lee, S.H.; Farh, M.E.; Lee, J.J.; Oh, Y.T.; Cho, E.B.; Park, J.; Son, H.; Jeon, J. A Histone deacetylase, Magnaporthe oryzae RPD3, regulates reproduction and pathogenic development in the rice blast fungus. mBio 2021, 12, e0260021. [Google Scholar] [CrossRef]
- Kurdistani, S.K.; Grunstein, M. Histone acetylation and deacetylation in yeast. Nat. Rev. Mol. Cell Biol 2003, 4, 276–284. [Google Scholar] [CrossRef] [PubMed]
- Xu, H.; Ye, M.; Xia, A.; Jiang, H.; Huang, P.; Liu, H.; Hou, R.; Wang, Q.; Li, D.; Xu, J.R.; et al. The Fng3 ING protein regulates H3 acetylation and H4 deacetylation by interacting with two distinct histone-modifying complexes. New Phytol. 2022, 235, 2350–2364. [Google Scholar] [CrossRef] [PubMed]
- Bruno, K.S.; Tenjo, F.; Li, L.; Hamer, J.E.; Xu, J.R. Cellular localization and role of kinase activity of PMK1 in Magnaporthe grisea. Eukaryot. Cell 2004, 3, 1525–1532. [Google Scholar] [CrossRef]
- Kim, D.; Langmead, B.; Salzberg, S.L. HISAT: A fast spliced aligner with low memory requirements. Nat. Methods 2015, 12, 357–360. [Google Scholar] [CrossRef] [PubMed]
- Love, M.I.; Huber, W.; Anders, S. Moderated estimation of fold change and dispersion for RNA-seq data with DESeq2. Genome Biol. 2014, 15, 550. [Google Scholar] [CrossRef] [PubMed]
- Zhang, S.; Guo, Y.; Li, S.; Zhou, G.; Liu, J.; Xu, J.; Li, H. Functional analysis of CfSnf1 in the development and pathogenicity of anthracnose fungus Colletotrichum fructicola on tea-oil tree. BMC Genet. 2019, 20, 94. [Google Scholar] [CrossRef]

Publisher’s Note: MDPI stays neutral with regard to jurisdictional claims in published maps and institutional affiliations. |
© 2022 by the authors. Licensee MDPI, Basel, Switzerland. This article is an open access article distributed under the terms and conditions of the Creative Commons Attribution (CC BY) license (https://creativecommons.org/licenses/by/4.0/).
Share and Cite
Guo, Y.; Chen, Z.; Li, H.; Zhang, S. The CfSnt2-Dependent Deacetylation of Histone H3 Mediates Autophagy and Pathogenicity of Colletotrichum fructicola. J. Fungi 2022, 8, 974. https://doi.org/10.3390/jof8090974
Guo Y, Chen Z, Li H, Zhang S. The CfSnt2-Dependent Deacetylation of Histone H3 Mediates Autophagy and Pathogenicity of Colletotrichum fructicola. Journal of Fungi. 2022; 8(9):974. https://doi.org/10.3390/jof8090974
Chicago/Turabian StyleGuo, Yuan, Zhenhong Chen, He Li, and Shengpei Zhang. 2022. "The CfSnt2-Dependent Deacetylation of Histone H3 Mediates Autophagy and Pathogenicity of Colletotrichum fructicola" Journal of Fungi 8, no. 9: 974. https://doi.org/10.3390/jof8090974
APA StyleGuo, Y., Chen, Z., Li, H., & Zhang, S. (2022). The CfSnt2-Dependent Deacetylation of Histone H3 Mediates Autophagy and Pathogenicity of Colletotrichum fructicola. Journal of Fungi, 8(9), 974. https://doi.org/10.3390/jof8090974

